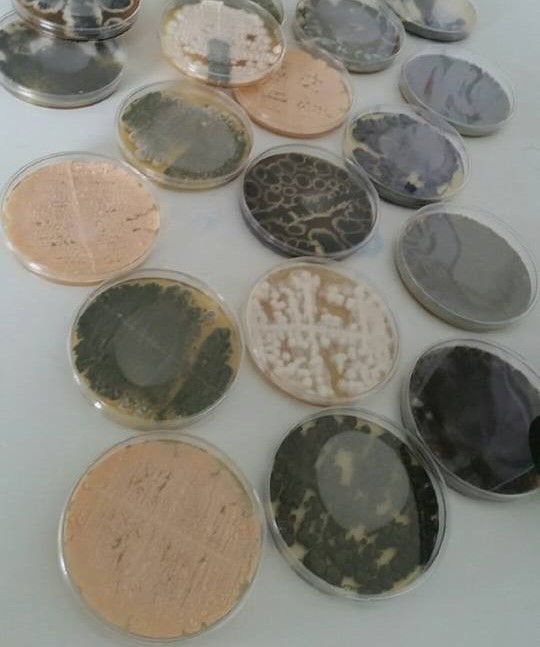

-
 27
27
MaiLe kit Acaritest – détection des allergènes d’acariens, test en vente en ligne
Acaritest est un dispositif qui vous permet de contrôler le niveau d’allergènes d’acariens auquel vous êtes exposé. Plus vous êtes exposés à des quantités importantes d’acariens, plus…
modif-anlyz no responses -
 13
13
AvrLe Biocollecteur d’air Coriolis µ utilisé pour la collecte du Coronavirus
Les biocollecteurs d'air Coriolis µ sont actuellement utilisés en Chine et en Europe pour collecter le coronavirus SARS-CoV-2, responsable de la pandémie COVID-19, et évaluer…
modif-anlyz no responses -
 21
21
FévUne nouvelle recrue chez Analyzair !
Après 13 ans passés à travailler dans des laboratoires d’analyses médicales, Marine Cauche, technicienne titulaire d’un DUT Génie biologique « Analyses Biologiques et Biochimiques »,…
modif-anlyz no responses -
 30
30
AoûtAnalyzair recrute !
Technicien en aérobiologie – H/F Présentation de l’entreprise : Vous souhaitez rejoindre une équipe jeune et dynamique au sein d’une start-up en aérobiologie ? Analyzair…
modif-anlyz no responses -
 19
19
AvrAnalyzair était présent au 14ème Congrès Francophone d’Allergologie
Analyzair était présent au 14ème Congrès Francophone d’Allergologie qui a eu lieu du 16 au 19 avril 2019 au Palais des Congrès de Paris. Nous…
modif-anlyz no responses -
 01
01
AvrAnalyzair était présent au congrès scientifique et technique ContaminExpert
Analyzair était présent au salon ContaminExpo et au congrès scientifique et technique ContaminExpert qui se déroulait du 26 au 28 Mars à Paris, porte de…
modif-anlyz no responses -
 21
21
DécUne nouvelle CMEI chez Analyzair !
Analyzair a le plaisir de vous annoncer la réussite de Jennifer Charbonnier au DIU Santé Respiratoire et Habitat qui lui permet de rejoindre la grande…
modif-anlyz no responses -
17
17
AoûtBientôt la fin des stages… Analyzair vous laisse découvrir le sujet d’Adeline !
Dans le cadre de mon stage de fin d’étude sur le sujet : « Détection et détermination des moisissures de l’air extérieur ayant un impact sur la…
modif-anlyz no responses -
 20
20
JuilVous êtes régulièrement victimes de rhinite ou de conjonctivite ? Vous êtes peut être allergiques aux moisissures !
Pour coloniser leur espace et s’y développer, les moisissures libèrent dans l’atmosphère des quantités parfois importantes de spores. On retrouve ces spores tout au long…
modif-anlyz no responses -
 12
12
JuilDégâts des eaux, logements humides, et si Stachybotrys s’installait dans votre maison ?
Un logement humide à cause d’inondations, de fuites et/ou d’infiltrations d’eau ? Surveillez attentivement la présence de Stachybotrys. Cette moisissure se développe dans des conditions…
modif-anlyz no responses